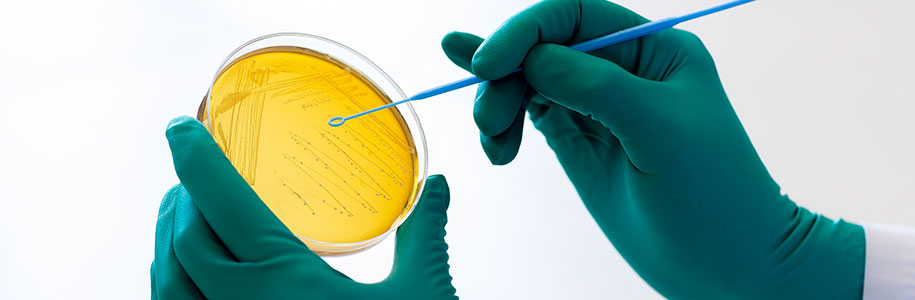

LOADING...
º´¸¶°³ÀÇ Ä¡¼öµîÀ» Á¤È®È÷ ÃøÁ¤ÇÒ ¼ö ÀÖ´Â 3Â÷¿ø ÃøÁ¤±â¸¦ µµÀÔÇÏ¿© ¾çÁúÀÇ º´¸¶°³¸¦ »ý»êÇϴµ¥ ÃÖ¼±À» ´ÙÇϰí ÀÖ½À´Ï´Ù.

°øÀå³» ÀÛ¾÷Àå ¹× »ý»êÇöÀå¿¡¼ÀÇ ¼¼±Õ°¨¿°µî ¹®Á¦Á¡À» »çÀü¿¡ Â÷´ÜÇϱâ À§ÇÏ¿© Á¤±âÀûÀ¸·Î ¼¼±Õ°Ë»ç¸¦ ½Ç½ÃÇϰí ÀÖ½À´Ï´Ù.
½ÃÁß¿¡¼ À¯ÅëµÇ°í ÀÖ´Â Á¦Ç°À» ÁÖ±âÀûÀ¸·Î ±¸ÀÔÇÏ¿© º´¸¶°³ÀÇ ¼º´É È®ÀÎ, Á¦Ç°Áú, µðÀÚÀÎµî º´¸¶°³ °ü·Ã ¸ðµç Á¤º¸¸¦ ¼öÁýÇÏ¿© ǰÁú°ü¸® ¹× ¿¬±¸°³¹ßÀÇ ±âÃÊÀÚ·á·Î Ȱ¿ëÇÏ°í ¾çÁúÀÇ Á¦Ç°°ø±ÞÀ» À§ÇÏ¿© ²÷ÀÓ¾øÀÌ ³ë·ÂÇϰí ÀÖ½À´Ï´Ù.












